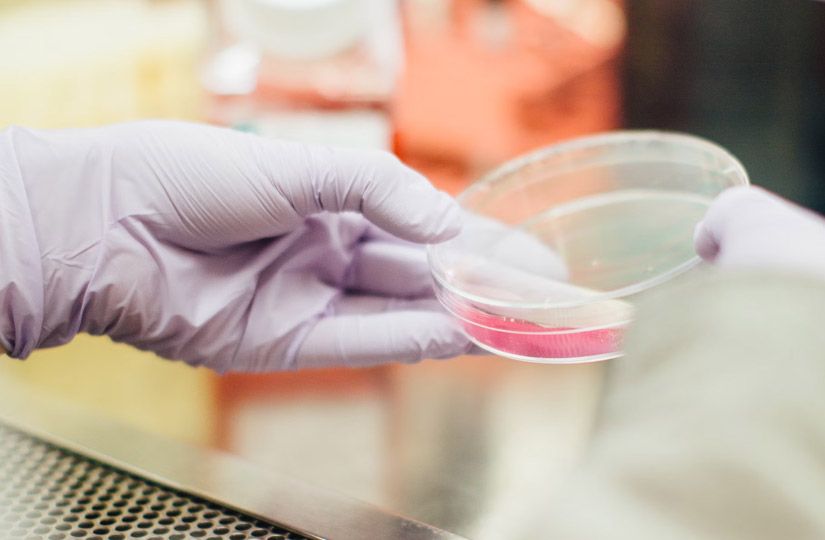

Пустой кошелёк и никакой пользы: вся правда о детоксе и шлаках
Согласитесь, как замечательно было бы за короткое время очистить организм, усилить работоспособность и обрести позитивное отношение к жизни. Особенно если для этого требуется всего лишь пить «волшебные» капсулы или один день в неделю питаться смузи. Вот почему так популярны различные методики детокса — процесса, который якобы избавляет организм от токсинов. Избавляет от того, чего на самом деле не существует…

Фото: freepik.com
Два настоящих детокса и один придуманный
Итак, вспомним рекламные обещания маркетологов. Под детоксом они подразумевают процесс очищения организма от накопившихся продуктов обмена. Причины «загрязнения» банальны: плохая экология, неправильное питание, малоподвижный образ жизни. При этом кишечник, печень, почки, кожа (то есть буквально все органы) выходят из строя и грозят нам вздутиями, прыщами, лишним весом и снижением иммунитета. И здесь маркетинговое попадание стопроцентное: похожие симптомы в той или иной степени может найти у себя любой человек, а значит, и детокс должен помочь всем без исключения.
Фото: unsplash.com
А теперь к фактам. Научное название детокса — детоксикация. В медицине ее разделяют на естественную и искусственную.
- Естественная детоксикация — самостоятельное удаление организмом всех продуктов обмена. Например, удаление углекислого газа через легкие или молочной кислоты через кожу. Главные органы детоксикации — печень и почки.
- Искусственная детоксикация — ряд медицинских процедур, проводящихся строго в больницах и под контролем врачей: гемодиализ, нейтрализация ядов и т. д.

Фото: freeimages.com
Токсины и шлаки: как избавиться от того, чего нет
Основа любой теории детокса и причина всех «бед» — шлаки и токсины: якобы именно их следует вывести из организма, чтобы зажить полноценной жизнью. Так что же это такое?
В токсикологии токсинами называют биологические яды: например, яды змей, продукты жизнедеятельности бактерий и вирусов. Детокс-теоретики смотрят на термин шире и подразумевают под токсинами любые потенциально вредные вещества: тяжелые металлы, нитраты и т. д. Ничего критичного в таком обобщении нет, но нужно понимать, что яд делает ядом концентрация: даже у обычной воды есть смертельная для человека доза. Еще вероятнее серьезное отравление ртутью, пестицидами, ботулотоксином, но, во-первых, их нужно еще поискать в таких количествах, а во-вторых, тяжелое отравление невозможно не заметить, продолжая жить обычной жизнью.

Фото: freepik.com
И если термин «токсины» можно еще хоть как-то оправдать, то со шлаками история куда более запутанная. Скорее всего, такое понятие появилось по аналогии со шлаком на стенах доменных печей. Это отходы добычи металла, которые действительно нужно удалять. Но человеческий организм не печь! Иногда можно встретить упоминания о «слизистых бляшках» в кишечнике, от которых может избавить тот или иной препарат, но доказательной медицине неизвестен не только состав этих бляшек, но и факт их существования.

Фото: freepik.com
Мнение доказательной медицины
Вердикт ученых по поводу детокса неутешителен: ни одна из представленных методик не имеет доказательной базы и представляет собой не более чем псевдонаучные доводы с подменой понятий. Результативность «детоксикации» зависит от силы самовнушения и эффекта плацебо, а «выздоровление» происходит естественным путем ввиду отсутствия самой болезни.

Фото: freepik.com
Вред детокса и детокс-диет
В лучшем случае детокс-пилюли и программы не принесут организму ожидаемой пользы, в худшем могут причинить вред.
Например, одна из самых популярных идей — это очищение и ускорение работы печени. Чаще всего фигурирует при этом расторопша. Однако даже в исследованиях, проводимых при лечении пациентов с циррозом, не только не нашлось убедительных доказательств полезного воздействия этой травы, но и была выявлена потенциальная опасность ряда БАД на ее основе. Что уж говорить о здоровой печени, которую и вовсе не нужно «ускорять».

Фото: freeimages.com
Многие препараты с пометкой detox обладают слабительным действием, и их регулярный прием может вызвать обезвоживание и электролитный дисбаланс в организме, а также нарушение моторной функции кишечника.
С опаской нужно относиться и к детокс-диетам любой продолжительности. В то время как нутрициологи твердят о важности разнообразного рациона и баланса питательных веществ, детокс предлагает рацион, наоборот, сузить, иногда до одного-двух продуктов. Стресс организма и дефицит важных нутриентов точно не стоят пары килограммов, ушедших за период детокса (в основном только за счет потери воды). А про вредоносные шлаки мы уже написали выше.

Фото: freeimages.com
Рациональный подход к детоксу
Лучший «детокс» — здоровый образ жизни, сбалансированное питание и физическая активность. Однако это требует ежедневных усилий, поэтому идея «волшебной таблетки» и разгрузочные дни до сих пор кажутся людям более привлекательными.

Фото: freeimages.com
Напомним простые правила, которые помогут почувствовать легкость и повысить настроение без всяких шарлатанских детоксов.
- Следите за рационом: соблюдайте баланс нутриентов, отдавайте предпочтение минимально обработанным продуктам, не забывайте про фрукты, овощи и другие источники клетчатки, а также белок (рекомендованные нормы — 1,5 г на кг веса для женщин и 2 г для мужчин). И, конечно, максимально ограничьте употребление фастфуда, выпечки, алкоголя и т. д.
- Пейте достаточное количество жидкости (30–40 мл на кг веса, из них 50% должно приходиться на воду).
- Больше двигайтесь: ходите пешком, занимайтесь спортом.
- Гуляйте. По возможности часть физической активности перенесите на свежий воздух.
- Высыпайтесь (спать следует не менее семи часов в сутки) и следите за своим биологическим ритмом.
И если уж вам так хочется попрактиковать какой-нибудь кратковременный детокс, пусть это будет сознательный отказ от гаджетов. Подробнее о том, кому он особенно нужен, мы писали здесь.

Фото: freeimages.com
















